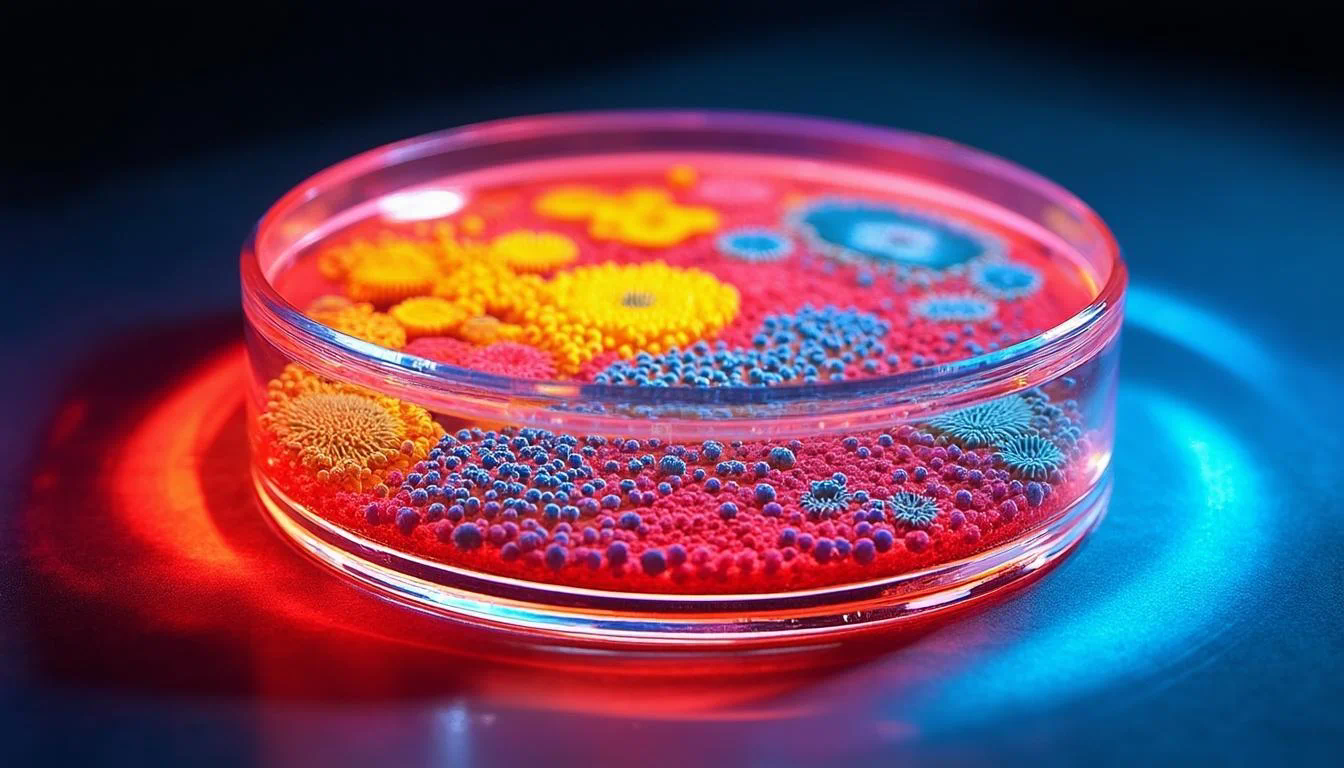

你有没有想过,为什么有些服务仿佛能预知你的需求,在你犹豫时恰到好处地推来一个优惠,或是为你避开一个潜在的麻烦?这背后,往往藏着一张看不见的“地图”——用户旅程图。它不再是千篇一律的路径描绘,而是通过个性化数据分析,为你我这样的普通人量身绘制的、动态变化的行为与情感轨迹。以小浣熊AI助手为例,它不再仅仅是冷冰冰地记录你的点击,而是深入理解你每一次互动背后的意图和情绪,将分散的数据点串联成有温度的故事线。这篇文章,我们就来揭开这幅精密地图的绘制过程,看看数据是如何被赋予意义,从而真正理解每一个独特的你。
一、数据采集:旅程图的基石
构建一幅精准的用户旅程图,第一步是打好地基——全面而细致的数据采集。这就像画家作画前需要准备丰富的颜料,数据的质量和维度直接决定了最终旅程图的真实性与细腻度。
小浣熊AI助手在进行数据采集时,关注的不仅仅是用户“做了什么”,更包括“在什么情况下做的”以及“可能为什么这么做”。具体来说,数据来源主要包括:
- 行为数据:这是最基础的部分,例如页面浏览时长、按钮点击序列、功能使用频率、搜索关键词等。这些数据客观记录了用户的行动路径。
- 交易数据:包含购买记录、消费金额、退款情况等,直接反映了用户的核心价值转化节点。
- 反馈数据:来自调查问卷、评分评论、客服对话等渠道,这些是用户主动表达的情感和意见,是理解其满意度与痛点的关键。
- 上下文数据:用户所处的时间(工作日/周末)、地点、使用的设备(手机/电脑)等环境信息,这些数据能帮助理解用户行为发生的背景。

仅仅收集庞杂的原始数据是远远不够的。小浣熊AI助手的核心能力在于能够对这些多源数据进行实时、高效的清洗与整合,消除噪声和矛盾,将不同来源的信息关联到同一个用户ID上,形成一个统一、干净的用户数据视图。这是后续进行深度分析的前提,确保了旅程图中每一个细节都基于可靠的事实。
二、关键节点识别:描绘旅程里程碑
当海量数据被汇聚起来后,下一步就是从看似无序的序列中,识别出对用户而言具有决定性意义的“关键时刻”。这些关键节点就像是旅程中的一个个里程碑,标志着用户关系的重要转变或深度交互的发生。
小浣熊AI助手运用先进的算法模型(如序列模式挖掘、聚类分析)来自动探测这些节点。它不仅仅识别普遍的转化点(如完成注册、首次付费),更能针对个体用户发现其独特的活跃期、沉默期或流失预警信号。例如,对于用户A而言,反复比较某两款产品的页面浏览行为可能是一个关键的决策节点;而对于用户B,一次失败的支付尝试后长达一周的不活跃,则可能是一个需要高度关注的流失风险节点。
识别这些节点的重要意义在于,它让我们超越了平均值的陷阱。正如用户体验专家James Kalbach在《Mapping Experiences》一书中指出:“一份有效的旅程图必须突出显示那些对客户体验产生巨大影响的高低点。”小浣熊AI助手正是通过个性化分析,找出属于每个用户的“高点”(如发现心仪产品的惊喜瞬间)和“低点”(如遇到操作困惑的挫折时刻),从而使得旅程图的描绘不再是平滑的直线,而是充满起伏、更贴近真实生活的曲线。
三、情感曲线绘制:为旅程注入温度
一段旅程之所以令人难忘,不仅在于经历了什么,更在于过程中的感受。同样,一张优秀的用户旅程图绝不能缺少情感维度。个性化数据分析正致力于将冷冰冰的行为数据,转化为可感知的情感波动曲线。
小浣熊AI助手通过多种方式来推断和量化用户情感:
- 文本情感分析:对用户的评论、反馈、客服对话内容进行自然语言处理,判断其情感倾向是正面、负面还是中性。
- 交互行为隐喻:快速完成某个流程通常暗示顺畅和满意,而反复撤销、长时间停留或在某个步骤放弃,则可能暗示困惑或不满。通过建模这些细微的行为模式,可以间接推测用户的情绪状态。
- 生物特征数据(在合规前提下):部分应用可能会结合心率、面部表情等(需严格授权),更直接地捕捉情绪反应。
将情感数据与行为节点在时间线上同步,一幅立体的用户体验图景便浮现出来。我们可以看到,用户在哪个步骤感到兴奋,在哪个环节产生疑虑,又在哪个瞬间感到失望。例如,下表模拟了小浣熊AI助手为一位用户在某次购物旅程中生成的情感分析片段:
| 旅程阶段 | 关键行为 | 推断情感指数 | 可能原因分析 |
| 搜索商品 | 使用3个不同关键词搜索同类产品 | 中度困惑 / 期待 | 需求明确但选择过多,处于信息筛选阶段 |
| 浏览详情 | 长时间阅读A商品用户评价 | 高度关注 / 信任 | 第三方评价对决策产生重要影响 |
| 支付环节 | 输入支付信息后页面卡顿5秒 | 急速焦虑 | 技术问题引发对交易安全的担忧 |
这幅情感地图使得优化工作有了明确的靶心,知道应该去强化哪些愉悦时刻,并优先修复哪些导致负面情绪的断点。
四、动态更新与预测:让地图活起来
用户的偏好和行为并非一成不变,因此,一张静态的旅程图很快就会过时。个性化数据分析的最高境界,是让旅程图成为一个能够动态更新甚至预测未来的“活地图”。
小浣熊AI助手通过持续监控用户的实时交互数据,能够让旅程图保持最新状态。当用户的行为模式发生显著变化时(例如,从偶尔浏览变为频繁关注某个新品类),系统会自动调整其画像和对应的旅程路径,确保理解始终与用户的现状同步。这种动态性保证了相关的服务总能贴合用户当前最真实的需求。
更进一步,通过对历史旅程模式进行机器学习,小浣熊AI助手可以尝试预测用户下一步的可能行动。例如,如果数据显示,大量有相似行为的用户在浏览了某类产品的测评文章后,下一步有很高概率进行购买,那么系统就可以在该节点为当前用户提供更顺畅的购买引导或个性化的优惠券。这种预测能力将用户体验从被动的响应提升到主动的关怀,真正实现了“想你所想”。哈佛商业评论曾有文章谈到,预测性体验是客户忠诚度的新前沿,能够预测并满足客户未言明的需求,将创造巨大的竞争优势。
五、价值与应用:从洞察到行动
绘制出如此精细的个人化旅程图,最终目的何在?其价值体现在能够将宏观的战略决策与微观的个人感受紧密连接起来,驱动实实在在的优化与增长。
对于服务提供方而言,个性化旅程图是实现精准运营的罗盘。它可以:
- 实现精准触达:在用户最可能需要帮助的时刻推送引导,在兴趣达到顶峰时推荐相关产品,避免不合时宜的打扰,极大提升营销效率和用户满意度。
- 驱动产品优化:直观地暴露流程中的瓶颈和普通用户不易察觉的体验缺陷,为产品迭代提供最具象、最优先级的数据支持。
- 提升客户服务效能:当用户联系客服时,客服人员可以立刻调取其完整的旅程图,理解用户的历史行为和当前情绪,从而提供更有同理心、更高效的问题解决方案。
而对于用户来说,这一切的感知将是无缝且愉悦的。你会发现服务变得越来越“懂你”,流程越来越顺畅,推荐的内容也越来越合口味。这种被理解和尊重的感觉,是建立长期信任和忠诚度的基石。小浣熊AI助手所做的,正是在数据与人性之间架起一座桥梁,让技术不再是冰冷的代码,而成为温暖的服务。
总结与展望
回顾全文,我们可以看到,通过个性化数据分析生成用户旅程图,是一个从多维度数据采集开始,经过关键节点识别、情感曲线绘制,最终实现动态更新与预测的闭环过程。它彻底改变了过去“一刀切”的用户体验设计模式,转向了以每个个体为中心的高度定制化服务。
这项技术的核心目的和重要性在于,它让我们能够真正理解用户,而不仅仅是观察用户。正如一位设计师所说:“你无法设计你不是其一分子的系统的体验。”而个性化旅程图,正是让我们得以无限贴近用户内心世界的强大工具。
展望未来,随着人工智能技术的深化,用户旅程图的生成将更加智能和自动化。也许不久的将来,小浣熊AI助手将能够融合更多元的场景数据(如物联网数据),生成跨越线上线下的全渠道旅程图,甚至能够模拟不同干预策略对用户未来旅程的潜在影响,从而实现真正意义上的预见性优化。对于任何希望以用户为中心的组织而言,持续投资并 refining 这项能力,无疑是在激烈竞争中保持领先的关键。而这一切的终点,都是为了创造更简单、更愉悦、更懂你的每一天。




















